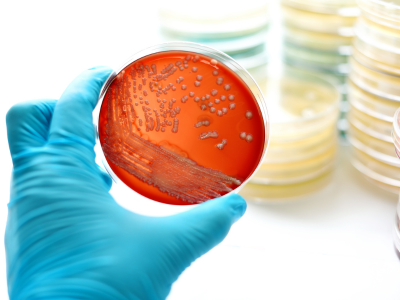
11 11

Bacterial WGS
No compromises on quality. Highly accurate and complete genomes. Plasmids included.

How it works?
Easy submission
You want to submit strains and get the sequence? Or are you looking for help in a complex project. PathoSense can aid in both situations and offers easy sample submission and fluent customer interaction.
In-depth sequencing
We don't compromise on quality because we know that a high sequencing depth (~100X) has advantages for downstream bioinformatics analyses. Using long reads, we can get circular genomes and plasmids.
Bacteriology expertise
A complex project or difficult question? We can take the extra mile and provide our customers with biological insightful results based on high quality sequences. PathoSense is the way to go for complex bacterial WGS projects.
What customers say
"Lorem ipsum dolor sit amet, consectetur adipiscing elit. Duis accumsan velit sit amet sagittis malesuadadfafafads."
"Lorem ipsum dolor sit amet, consectetur adipiscing elit. Duis accumsan velit sit amet sagittis malesuadadfafafads."
"Lorem ipsum dolor sit amet, consectetur adipiscing elit. Duis accumsan velit sit amet sagittis malesuadadfafafads."
Our experts are here to help you
All samples are not equal. Some samples require specific enrichment strategies to get the most data out. PathoSense has ample experience with conventional samples (eg. feces, cecum content...) and low-biomass samples (eg. respiratory mucus, vaginal samples etc). This allows you to explore microbial communities in a variety of sample types.
At PathoSense we use long-read sequencing to analyse the microbiome in the most insightful way. One approach is the amplification of the complete 16S rRNA gene fragment (~1500 bp) so that we can sequence it entirely. This gives advantages for the taxonomical identification with the classification of bacteria up to the species level. Another approach is shotgun metagenomics. Here, DNA is isolated in crude fractions and long strands of bacterial DNA can be used after sequencing to assemble partial and complete bacterial genomes. These assembled metagenomes can be exploited for downstream functional characterisation (see further).
The first insight in the microbial community starts with the members that are there. Using full-length 16S rRNA gene sequencing we can determine bacterial compositions up to genus and species level. Using metagenomic assemblies, we can even go deeper and determine whether specific strains of interest are present in samples.
PathoSense guides you with the statistical analysis of your studies. Alpha diversity will analyse the bacterial diversity within certain samples, whereas beta diversity will compare the microbiome diversity between different treatments. Everything is reported with insightful graphs and explained during a follow-up meeting. To get the most out of your data, we can rely on the most advanced statistical analysis methods tailored to your needs.
When metagenomic assemblies are available, we can dig deeper into the functionality of the microbiome. Pathogenic bacteria harbour virulence markers that can be identified with scientifically validated databases. Furthermore, one might be interested to see whether certain treatments affect the presence of antimicrobial resistance gene markers or if certain beneficial genes are found on the contrary. This is state-of-the-art research and we are happy to take you along in this exciting field.
PathoSense collaborates with the LANUPRO laboratory of Ghent University from prof. Jeroen Degroote. A direct measurement of the microbiome's metabolites can be performed to see which concentrations of short-chain fatty acids, lactic acid and ammonia are found. This information can then be linked further to the presence of certain bacteria in the microbial communities.
Looking for the best quality?
Feature
Easy submission
Target depth
Assembly quality
Biological insights
Support available
Standard provider
yes
30x-50x
Q40
do it yourself
limited
PathoSense
yes
>100x
+Q50
guidance by experts
yes
€€€
PathoSense in scientific articles

- Predictive Power of Long-Read Whole-Genome Sequencing for Rapid Diagnostics of Multidrug-Resistant Brachyspira hyodysenteriae Strains. Vereecke et al., 2023, Microbiology spectrum - read more
- The Genetic Landscape of Antimicrobial Resistance Genes in Enterococcus cecorum Broiler Isolates. Huang et al., 2024. Antibiotics (Basel) - read more
- Phenotypic and genotypic assessment of iron acquisition in diverse bovine-associated non-aureus staphylococcal strains. Reydams et al. 2024, Veterinary Research - read more
- Genomic mining of Vibrio parahaemolyticus highlights prevalence of antimicrobial resistance genes and new genetic markers associated with AHPND and tdh + /trh + genotypes. Vandeputte et al., 2024, BMC Genomics - read more
- Genome-Wide Association Study Reveals Genetic Markers for Antimicrobial Resistance in Mycoplasma bovis. Bokma et al., 2021, Microbiology Spectrum - read more